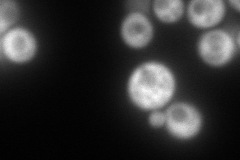
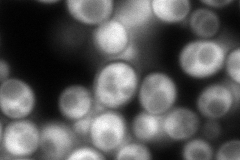
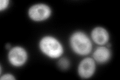
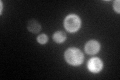

View description
Translation elongation factor EF-1 gamma
Localization:
Intensity:
Fold change:
Significance:
-
C’ GFP library in SD

cytosol969.3 -
N' NOP1pr-GFP in SD

cytosol181.625 -
N' TEF2pr-mCherry in SD
cytosol288.48 -
N' NATIVEpr-GFP in SD
cytosol286.072 -
N' TEF2pr-VC and Cyto-VN in SD

cytosol80.4183 -
C’ GFP library in SD+DTT
cytosol783.950.8No -
C’ GFP library in SD+H2O2

cytosol701.950.72No -
C’ GFP library in Starvation Media
cytosol141.130.14Yes -
C’ GFP library on the background of Pup2-DaMP

cytosol -
C’ GFP library on the background of CCT mutant

cytosol798.4790.823764No
